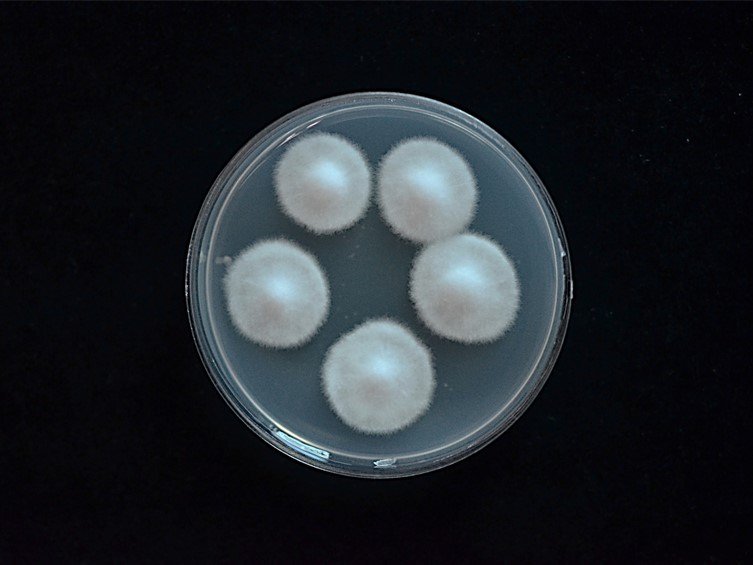

Holotype:
THAILAND, Khon Kaen Province, Phu Wiang National Park, 19 Jul. 2017, K. Tasanathai, S. Mongkolsamrit, W. Noisripoom, W. Himaman, P. Jangsantear, B. Sakolrak, holotype BBH 43364, ex-type living culture BCC 85074.
Habitat:
Buried in the ground.
Host:
Lepidoptera pupa.
Description:
 Stroma arising from the head of Lepidoptera pupa, cylindrical, solitary, simple, 18 mm long, 3 mm wide, purple. Upper part of the stroma fertile, fleshy, expanded, parted, 11 mm long, 3 mm wide, white to purple.
Stroma arising from the head of Lepidoptera pupa, cylindrical, solitary, simple, 18 mm long, 3 mm wide, purple. Upper part of the stroma fertile, fleshy, expanded, parted, 11 mm long, 3 mm wide, white to purple.  Perithecia immersed, oblique in arrangement, ovoid, 304-350 × 212.5-250 μm.
Perithecia immersed, oblique in arrangement, ovoid, 304-350 × 212.5-250 μm.  Asci cylindrical, 100-182 × 4-5 μm, apical cap prominent, 4-5 μm wide.
Asci cylindrical, 100-182 × 4-5 μm, apical cap prominent, 4-5 μm wide.  Ascospores smooth-walled, hyaline, filiform, 125-190 × 1 μm, whole, multi-septate. Asexual morph not seen in nature.
Ascospores smooth-walled, hyaline, filiform, 125-190 × 1 μm, whole, multi-septate. Asexual morph not seen in nature.
Culture characteristics:
Colonies on PDA attaining a diam of 15–17 mm in 7 d, white to cream, cottony, high mycelial density, reverse cream. Hyphae septate, smooth-walled, hyaline, 1–2 μm diam. Phialides arising from aerial hyphae, lecanicillium-like, hyaline, solitary or more often 2–4 in whorls on each branch, cylindrical, tapering gradually towards the apex, 5–17 × 1–3 μm. Conidia in long chains, hyaline, ovoid, 2–4 × 1.5–2 μm.
Colonies on PDA attaining a diam of 15–17 mm in 7 d, white to cream, cottony, high mycelial density, reverse cream. Hyphae septate, smooth-walled, hyaline, 1–2 μm diam. Phialides arising from aerial hyphae, lecanicillium-like, hyaline, solitary or more often 2–4 in whorls on each branch, cylindrical, tapering gradually towards the apex, 5–17 × 1–3 μm. Conidia in long chains, hyaline, ovoid, 2–4 × 1.5–2 μm.
Reference:
Mongkolsamrit S, Khonsanit A, Thanakitpipattana D, et al. (2020). Revisiting Metarhizium and the description of new species from Thailand. Studies in Mycology 95: 171–251.
DOI: https://doi.org/10.1016/j.simyco.2020.04.001Species |
Strain |
Compound |
Pubchem CID |
Biological activity |
Reference |
|---|
|
Strain |
ITS | LSU | RPB1 | RPB2 | TEF1 |
|---|---|---|---|---|---|
| BCC 85074 | - | MN781873 | MN781775 | MN781821 | MN781730 |
| BCC 85348 | MN781927 | MN781871 | MN781773 | MN781820 | MN781728 |
| BCC 85349 | MN781928 | MN781872 | MN781774 | - | MN781729 |